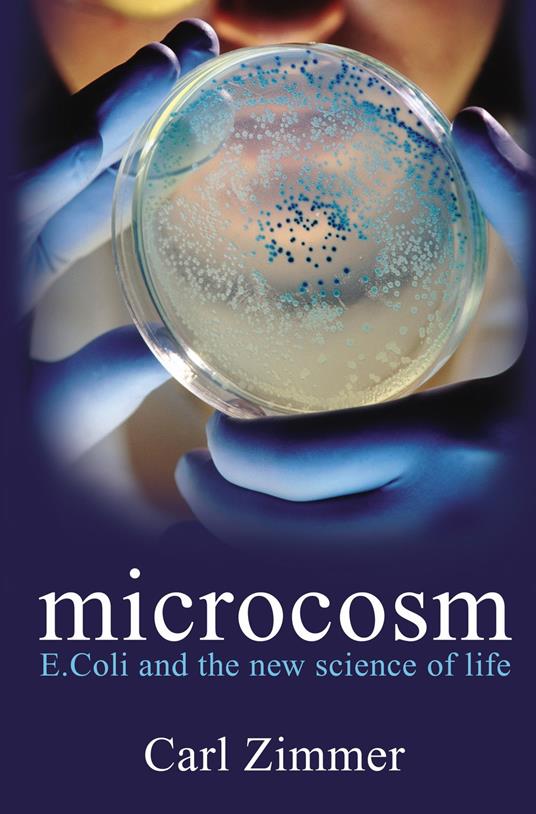
Microcosm

Microcosm
In 1946, a twenty-year-old medical school student called Joshua Lederberg decided to find out whether microbes make love. Lederberg was motivated not by a displaced libido, but by scientific ambition. At the age of seven, he had declared that he hoped to become 'like Einstein' and to 'discover a few things in science.' The 'few things' Lederberg discovered would revolutionise modern science and earn him a Nobel Prize. He chose to observe the breeding habits of a certain bacterium called Escherichia coli, better known as E coli. His experiments used defective E coli strains lacking the essential molecules to reproduce by cloning which should, by rights, perish in the petri dish. But slowly, a few colonies of survivors began to spread accross the dishes. The only possible explanation for their survival was that they were a product of sex. Not only had Lederberg proved that bacteria have sex, he had also proved they have genes. Since then, a bacterium that was once nothing more than a humble resident of the human gut has become our best guide to what it means to be alive. Most of us might only know E coli for its lethal strain that causes food poisoning, but Zimmer uses E coli as a prism to understand what life is, what it was, and what it will become. We learn how E coli microbes talk to each other, how studies of their evolution represent the most powerful evidence in support of natural selection, and how they might just explain life on other planets...
-
Autore:
-
Anno edizione:2012
-
Editore:
-
Formato:
-
Lingua:Inglese
Formato:
Gli eBook venduti da Feltrinelli.it sono in formato ePub e possono essere protetti da Adobe DRM. In caso di download di un file protetto da DRM si otterrà un file in formato .acs, (Adobe Content Server Message), che dovrà essere aperto tramite Adobe Digital Editions e autorizzato tramite un account Adobe, prima di poter essere letto su pc o trasferito su dispositivi compatibili.
Cloud:
Gli eBook venduti da Feltrinelli.it sono sincronizzati automaticamente su tutti i client di lettura Kobo successivamente all’acquisto. Grazie al Cloud Kobo i progressi di lettura, le note, le evidenziazioni vengono salvati e sincronizzati automaticamente su tutti i dispositivi e le APP di lettura Kobo utilizzati per la lettura.
Clicca qui per sapere come scaricare gli ebook utilizzando un pc con sistema operativo Windows